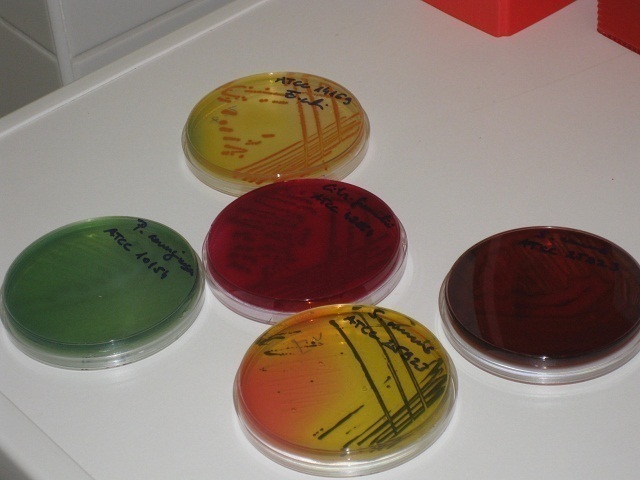

Minőség és megbízhatóság
Laboratórium
Laboratórium
A Budapest Gyógyfürdői és Hévizei Zrt. NAH-1-1264/2024 számon akkreditált Vízminőség-vizsgáló Laboratóriumának akkreditált műszaki területei:
- ivóvíz, felszín alatti víz, palackozott víz, ásványvíz és gyógyvíz mintavétele, helyszíni vizsgálata, fizikai, kémiai, bakteriológiai és mikroszkópos biológiai laboratóriumi vizsgálata,
- mesterséges fürdők medencevizének, tisztított vizének és tápvizének mintavétele, helyszíni vizsgálata, fizikai, kémiai és bakteriológiai laboratóriumi vizsgálata,
- természetes fürdők mintavétele, fizikai, kémiai és bakteriológiai laboratóriumi vizsgálata,
- felszíni vizek mintavétele, fizikai, kémiai és bakteriológiai vizsgálata.
Elérhetőségek:
Kovács Luca Bella laboratóriumvezető
Telefon: +36 1 209 3652
Mobil: +36 20 535 7336
e-mail: [email protected], [email protected]
1117 Budapest, Orlay utca 5-7.